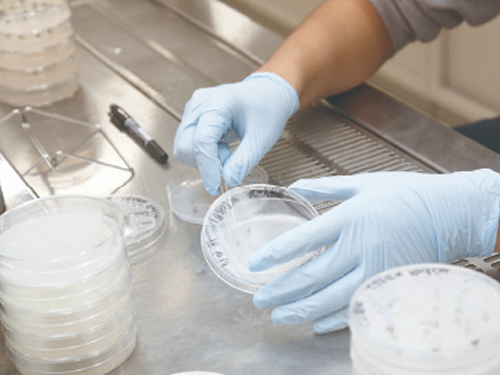

メディカルバイオサイエンス学科(~2023年度)
学科概要

医師などの専門職を支えて医療産業に従事する人材を育成するため、バイオサイエンスの知識や学びに加え、医療に関わる専門的な科目を学びます。医科学系、創薬科学系、医療情報系の学びを通して、遺伝情報や電子カルテなどを取り扱う上で必要な医療情報学の専門知識と、データベースなど医療情報を扱うIT技術を修得します。
(※2024年度 メディカルバイオサイエンス学科を改称しバイオデータサイエンス学科を開設)
医療の現場とIT技術
現代の医療分野は、AIの登場で新しい進化を遂げようとしています。医科学系、創薬科学系、医療情報系の学びを現代の高度化、専門化したバイオメディカル分野に生かし、医師や看護師、薬剤師などの専門職を支えて医療産業で活躍できる人材を育成します。
教育・学びの特色
バイオの学びと医療・医学の学びで、高度化した医療産業で活躍する人材を育成
医科学系、創薬科学系、医療情報系の学びを通して、遺伝情報や電子カルテなどを取り扱う上で必要な医療情報学の専門知識と、データベースなど医療情報を扱うIT 技術を修得します。医療・医学の学びを重視し、製薬、医療機器、医療IT など高度化・専門化した現代の医療産業や、化学メーカーなどで活躍できる人材を育成します。

メディカルバイオサイエンス学科ポリシー
育成する人物像

4年後の成長イメージ
- 基礎から実践に至るメディカルバイオサイエンスの知識と技術を修得し、医薬品、医用機器、臨床分析、化学、ITなどの分野で活躍できる。
- 語学力と情報処理能力で、高度情報化・国際化社会に対応できる。
- 主体的に学び、自ら課題を発見し、その解決法を導き出すとともに、他者と協力して物事にあたることができる。
カリキュラム・授業
「専門科目」として、以下の5つの科目群から必要な講義・実習を履修することで、メディカルバイオサイエンス研究の実践に必要な知識と技術を身につけます。
|
医療情報系 |
医科学系 |
創薬科学系 |
専門実験 |
|
|---|---|---|---|---|
|
1年次 |
コンピュータ・グラフィックス実習 人工知能入門 |
医学概論 実験動物学 |
||
|
2年次 |
人工知能の理論と実践 AIロボット製作実習 医療のための情報工学概論Ⅰ 医療のための情報工学概論Ⅱ 医用データベース技術Ⅰ 医用データベース技術Ⅱ 医用工学概論 立体解剖学 ゲノム解析学 |
神経科学 組織学 栄養学 動物生理学 動物生殖発生学 動物系統分類学 食品衛生学 |
医薬分子機能学 生体高分子解析学 放射線生物学 |
|
|
3年次 |
医療情報学概論 進化生物学 インシリコ創薬基礎実習 インシリコ創薬応用実習 |
病原ウイルス学 免疫学 公衆衛生学 病理学 細胞工学 発生生物学 薬理学 |
創薬科学概論 タンパク質工学 生理活性物質概論 構造生物学 生体材料工学 |
M 専門実験ⅠA(医科学系) M 専門実験ⅠB(創薬科学系) M 専門実験ⅡA(医科学系) M 専門実験ⅡB(創薬科学系) |
|
4年次 |
専門・総合 |
|||
| 文献調査・講読 卒業研究 |
||||
授業紹介
医療学系:ヒトの体の仕組みを深く学ぶ

医療科学に重要な医学、生理学、発生学、組織学、免疫学、病理学、薬理学などの科目を選択科目としています。直接患者と接する機会がなくても、あらゆる医療の現場で柔軟かつ的確に対応できる力を身につけます。
創薬科学系:くすりの仕組みや開発について学ぶ

医薬品や創薬、タンパク質などに関連した、創薬科学の専門性の高い科目を学びます。創薬の基礎から先端技術を学び、製薬会社より講師を招いて現場の生の声を聞く「創薬科学概論」など、最新の情報を取り入れた実践的な内容で理解を深めます。
医療情報系:医療に関わるビッグデータの取り扱いを学ぶ

人工知能やビッグデータの取り扱い、医療情報に関する科目を履修します。コンピュータ上に人体を再構築し、3Dで形態や構造を理解する「立体解剖学」、電子カルテの操作や健康保険の仕組みを学ぶ「医療情報学概論」など、新時代の医療人に求められる知識や技術を修得します。
専門実験
メディカルバイオサイエンス研究に必要な医科学系と創薬科学系の実験を「専門実験Ⅰ,Ⅱ」として必修で配置し、4年次の卒業研究へ向けた知識や技術を身につけます。
専門総合
4年次では集大成としての「卒業研究」と「文献調査・講読」を必修として配置し、実社会で活躍するために必要な能力を養います。
